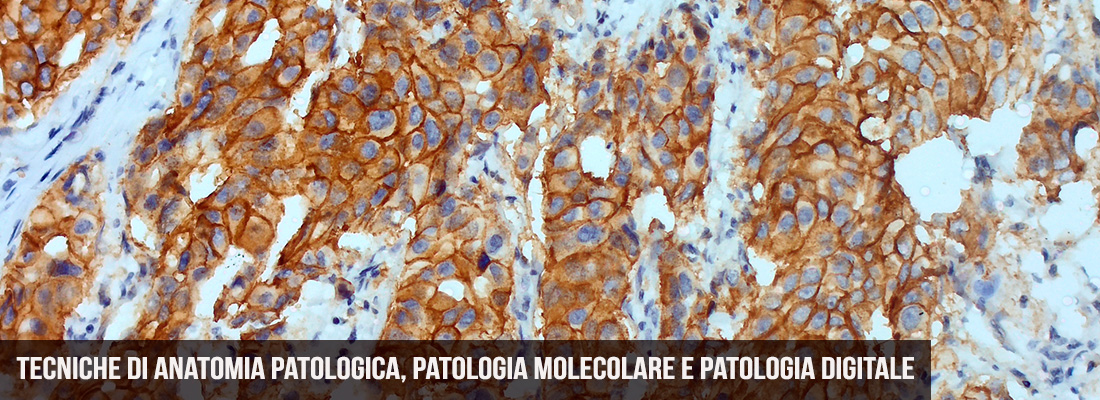
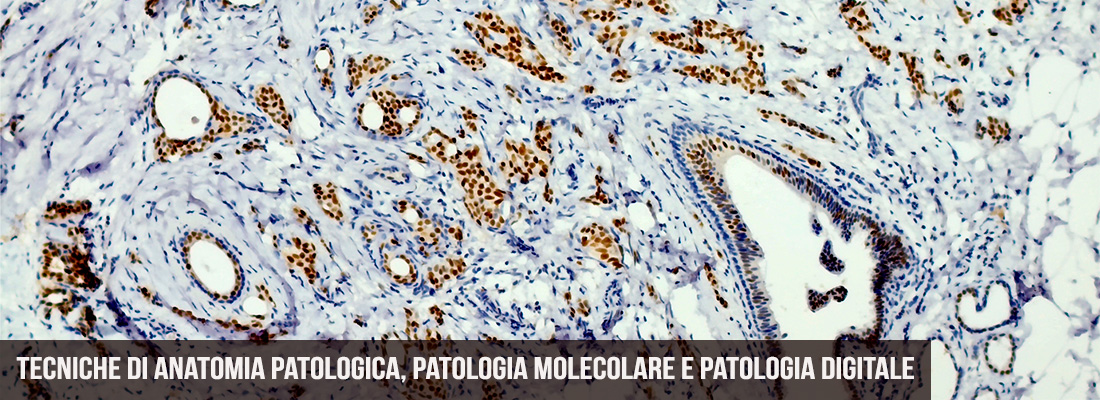

Il Master Universitario di I Livello in Tecniche di Anatomia Patologica, Patologia Molecolare e Patologia Digitale rappresenta un percorso formativo altamente specialistico, pensato per rispondere alle esigenze sempre più complesse della medicina diagnostica moderna. Rivolto a tecnici di laboratorio biomedico, biologi e medici, il Master si propone di fornire una preparazione integrata e multidisciplinare che unisca le solide basi delle tecniche istologiche e citologiche tradizionali con le più recenti innovazioni nell’ambito della patologia molecolare, della patologia digitale e dell’intelligenza artificiale applicata alla diagnostica.
L’evoluzione della medicina di precisione e l’introduzione di nuove tecnologie, come il sequenziamento di terza generazione, la digitalizzazione dei vetrini istologici, e i sistemi automatizzati di immunoistochimica, richiedono figure professionali altamente qualificate, in grado di coniugare conoscenze teoriche approfondite con competenze pratiche avanzate.
Il Master ANAPAT si distingue proprio per il suo approccio formativo innovativo, che integra:
- Lezioni frontali tenute da docenti universitari ed esperti del settore;
- Esercitazioni pratiche svolte in laboratori specializzati;
- Tirocini formativi presso prestigiose strutture ospedaliere e universitarie;
- Attività seminariali e workshop su tematiche emergenti.


 UNIVERSITA' DEGLI STUDI ROMA "TOR VERGATA"
UNIVERSITA' DEGLI STUDI ROMA "TOR VERGATA"